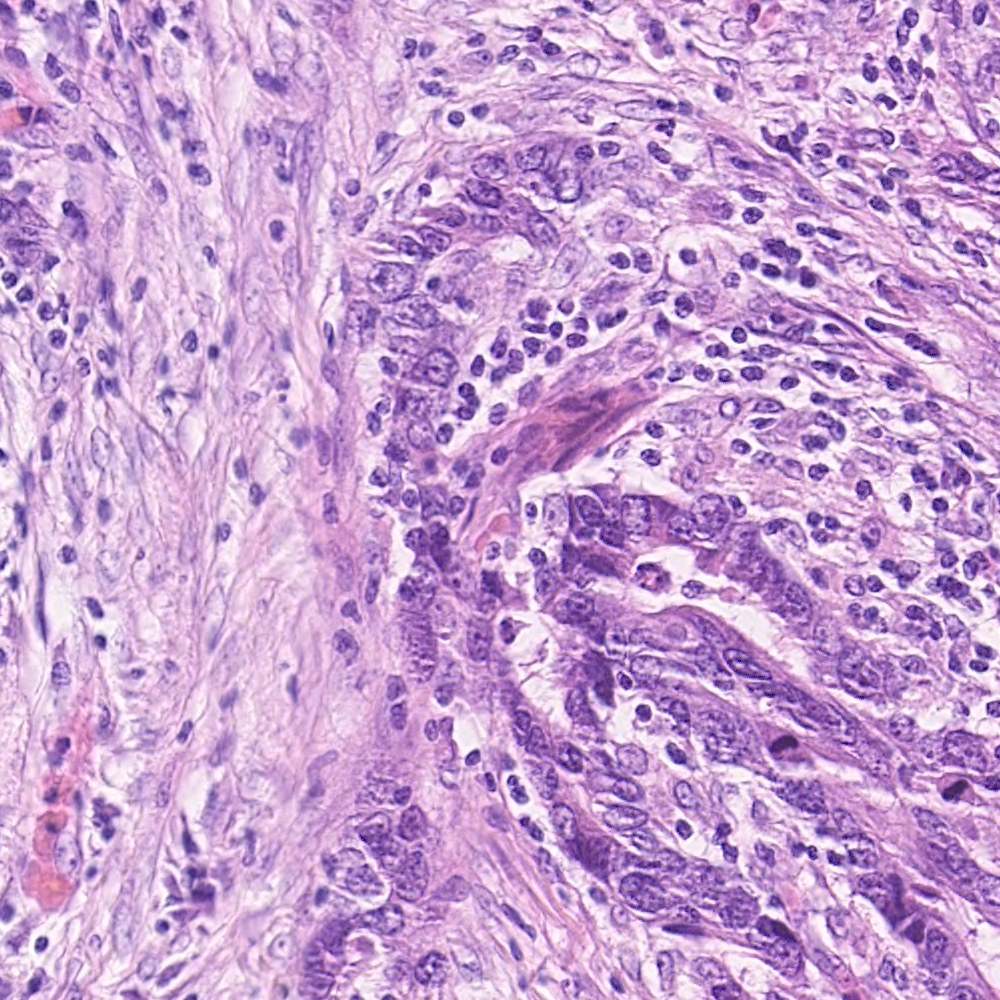

Commit
·
77fecc7
1
Parent(s):
e04b15b
add images
Browse files- sample_data/test_10.png +3 -0
- sample_data/test_2.png +3 -0
- sample_data/test_3.png +3 -0
- sample_data/test_4.png +3 -0
- sample_data/test_5.png +3 -0
- sample_data/test_6.png +3 -0
- sample_data/test_7.png +3 -0
- sample_data/test_8.png +3 -0
- sample_data/test_9.png +3 -0
sample_data/test_10.png
ADDED

|
Git LFS Details
|
sample_data/test_2.png
ADDED

|
Git LFS Details
|
sample_data/test_3.png
ADDED

|
Git LFS Details
|
sample_data/test_4.png
ADDED

|
Git LFS Details
|
sample_data/test_5.png
ADDED
|
Git LFS Details
|
sample_data/test_6.png
ADDED

|
Git LFS Details
|
sample_data/test_7.png
ADDED

|
Git LFS Details
|
sample_data/test_8.png
ADDED

|
Git LFS Details
|
sample_data/test_9.png
ADDED

|
Git LFS Details
|